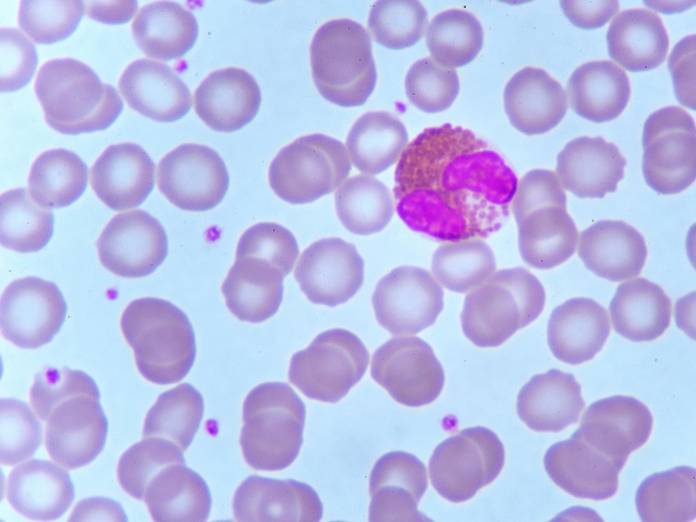

Die weißen Blutkörperchen (Leukozyten) haben eine wichtige Funktion in der Abwehr von Krankheitserregern. Sie gehören damit zum Immunsystem. Nach Funktion und Gestalt werden sie eingeteilt in
Granulozyten (lat. granulum: Körnchen und griech. cyto: Höhlung) sind mit einem Anteil von 50 bis 70 Prozent die größte Gruppe der Leukozyten. Ihre Aufgabe ist besonders die direkte Bekämpfung von Krankheitserregern (Parasiten, Bakterien, Pilze). Unterschieden werden neutrophile, basophile und eosinophile Granulozyten. Die Einteilung erfolgt anhand der Färbbarkeit der Granula im Blutausstrich. Sie führen unterschiedliche Funktionen aus.
Eosinophile Granulozyten machen einen Anteil von etwa ein bis fünf Prozent der Gesamtleukozytenzahl aus. Die Bezeichnung eosinophil („Eosin liebend“) beschreibt ihr Anfärbeverhalten. Durch den Farbstoff Eosin färben sie sich rötlich und sind so leicht von den anderen Granulozyten zu unterscheiden.
Hauptfunktion der Eosinophilen ist die Bekämpfung von Parasiten. Sie sind wesentlich beteiligt an allergischen Reaktionen. In den für Granulozyten typischen Granula (oder Vesikeln) haben sie bestimmte Inhaltsstoffe für diese Aufgabe gespeichert, die bei Bedarf freigesetzt werden. Zum einen Stoffe, die andere Zellen zerstören (zum Beispiel Major Basic Proteins und bestimmte Enzyme) und andere, die eine Entzündungsreaktion auslösen.
Die Bekämpfung von Parasiten läuft folgendermaßen ab: Eingedrungene Krankheitserreger werden von anderen Zellen des Immunsystems mit sogenannten Antikörpern gekennzeichnet. Dadurch werden die Eosinophilen angelockt und bewegen sich aktiv zu dem Eindringling. Sie docken an dem Antikörper an und setzen ihre zerstörenden Inhaltsstoffe frei, der Parasit wird abgetötet. Außerdem sind sie als sogenannte „Fresszelle“ in der Lage, Fremdlinge zu umschließen, in sich aufzunehmen und unschädlich zu machen (der Vorgang wird Phagozytose genannt). Eine weitere Rolle spielen sie bei der Entstehung von Allergien. Durch die Freisetzung Ihrer Inhaltsstoffe aufgrund eindringender Allergene (zum Beispiel Pollen) können typische Reaktionen wie Rötungen, Juckreiz oder Atemnot auftreten. Eosinophile können jedoch auch den eigenen Körper schädigen. Beim Asthma bronchiale beispielsweise wird die Lungenschleimhaut durch die Inhaltsstoffe geschädigt, dadurch mehr Schleim produziert und die Symptome verstärkt. Je nach betroffenem Organ fallen die Symptome unterschiedlich aus (Magenschmerzen, Kurzatmigkeit, Ausschlag).
| Immunzellen | Aufgabe und Funktion |
|---|---|
| neutrophile Granulozyten | Bekämpfen als Fresszellen Bakterien, Pilze und Viren im Blut (Phagozytose). |
| eosinophile Granulozyten | Wehren Parasiten ab und sind an allergischen Reaktionen beteiligt. |
| basophile Granulozyten | Wehren Parasiten ab und können allergische Reaktionen auslösen. Können ebenfalls an Entzündungsreaktion und Juckreiz beteiligt sein. |

Wie alle Granulozyten sind eosinophile kugelförmig.
Mit einer Größe von 12 bis 17 μm sind sie etwas größer als andere Granulozyten. Ihr Zellkern ist zweigelappt, bzw. brillenförmig. Mit Eosin lassen sich ihre Granula rötlich anfärben. Eosinophile Granulozyten kommen selten vor. Nur 3-5% aller weißen Blutkörperchen sind eosinophile Granulozyten.
Die Leukozyten werden im kleinen Blutbild untersucht. Liegt eine Veränderung des Wertes vor, folgt in der Regel ein großes Blutbild (Differentialblutbild und kleines Blutbild), das die einzelnen Unterarten der Leukozyten aufschlüsselt. Der Normwert für Eosinophile liegt bei 50 bis 250 Zellen pro μl Blut. Bezogen auf die Gesamtleukozytenzahl ist der Normalwert ein bis vier Prozent.
Eine Übersicht über das Differentialblutbild mit allen Normwerten gibt folgende Tabelle:
| Zellen | in Prozent | pro µl Blut | weitere Infos |
|---|---|---|---|
| Alle weißen Blutkörperchen (Leukozyten) | 100% | 4.000-10.000 | Leukozyten zu hoch Leukozyten zu niedrig |
| Neutrophile Granulozyten (segmentkernig) | 50-70% | 3.000-5.800 | Neutrophile zu hoch Neutrophile zu niedrig |
| Neutrophile Granulozyten (stabkernig) | 3-5% | 150-400 | |
| Basophile Granulozyten | 0-1% | 15-40 | Basophile zu hoch Basophile zu niedrig |
| Eosinophile Granulozyten | 1-4% | 50-250 | Eosinophile zu hoch Eosinophile zu niedrig |
| Monozyten | 3-7% | 285-500 | Monozyten zu hoch Monozyten zu niedrig |
| Lymphozyten | 25-45% | 1.500-3.000 | Lymphozyten zu hoch Lymphozyten zu niedrig |
Die Erhöhung der Eosinophilen im Blut wird auch als Eosinophilie bezeichnet.
Häufigste Ursachen sind Allergien, bestimmte Krebsarten oder Infektionen mit Parasiten. Allergische Erkrankungen, die zu einer Erhöhung der Eosinophilen führen sind z.B. allergische Rhinitis, Asthma, Ekzeme. Durch die Beteiligung der Eosinophilen und anderer Zellen kommt es zu den klassischen Symptomen wie Juckreiz, Ausschlag, Nasen- und Augenausfluss. Bestimmte Blutkrebsarten führen zu einer vermehrten Bildung von Granulozyten im Knochenmark und damit zu einer Erhöhung der Zellen im Blut (Leukämie, myeloproliferative Erkrankungen). Dringen Parasiten in den Körper ein und werden durch die körpereigene Abwehr erkannt und als Fremd markiert, können sich Eosinophile aktiv auf den Weg zu der Infektion machen. Sie folgen dabei chemischen Botenstoffen. Die Bekämpfung der Eindringlinge führt dazu, dass weitere Eosinophile angelockt werden. Es kommt zum Anstieg der Gesamteosinophilenzahl.
Symptome treten in der Regel erst auf, wenn die Eosinophilen stark erhöht sind. Dabei kann jedes Organ betroffen sein, mit entsprechend vielfältigen Symptomen. Betrifft es die Haut, kommt es zu Ausschlag. Ist die Lunge betroffen zu Kurzatmigkeit, bei Schädigung von Magen- oder Speiseröhre leiden Betroffenen unter Magenschmerzen. Die Erkrankung ist nach dem jeweils involvierten Organ benannt, z.B. Eosinophile Dermatitis (Haut), Eosinophile Gastritits (Magen), Eosinophile Pneumonie (Lunge).
Eine weitere Erkrankung, die mit einer Eosinophilie einhergeht, ist das Idiopathische Eosinophilie-Syndrom. Hier kommt es ohne ersichtlichen Grund über einen Zeitraum von mehr als sechs Monaten zu einer Erhöhung der Eosinophilen von über 1500 pro µl Blut. Je nach betroffenem Organ leiden Patienten unter unterschiedlichen Symptomen. Häufig kommt es zu Fieber, Gewichtsverlust, Magenschmerzen, Ausschlag oder Schwäche. Unbehandelt kann die Erkrankung zum Tode führen, die Ursache ist meist ein fortgeschrittener Herzschaden. Wird sie behandelt (zum Beispiel durch den Einsatz von Cortison), können etwa 80 Prozent der Betroffenen geheilt werden.
Eine Reduktion der Eosinophilenzahl wird als Eosinopenie bezeichnet.
Ursache ist eine vermehrte Cortisolausschüttung durch die Nebennieren bei Stress, sehr anstrengender Arbeit oder beim Cushing Syndrom. Durch die Einnahme von Cortison oder im Anfangsstadium schwerer Infektionskrankheiten (zum Beispiel Lungenentzündung, Typhus) können die Eosinophilen im Blut reduziert sein.
Da die Hauptaufgabe der Eosinophilen die Bekämpfung von Parasiten und die Beteiligung an allergischen Erkrankungen ist, deutet eine Erhöhung im Blut zunächst auf eine solche Erkrankung hin. Die Produktion von Eosinophilen im Knochenmark wird gesteigert, um eine ausreichende Reaktion auslösen zu können. Eine Verdachtsdiagnose wird durch das Auftreten weitere Symptome gestellt. Zur endgültigen Diagnosestellung werden gezielte Untersuchungen (Allergietest, Parasitenkontrolle, Gewebeproben) folgen. Ist eine Allergie die zu Grunde liegende Ursache, wird diese therapiert (Desensibilisierung, Meiden des Allergens). Parasiten werden mit entsprechenden Medikamenten bekämpft. Außerdem werden je nach betroffenen Organen die Symptome behandelt. Bei Vorliegen von bakteriellen Infektionen wird ein Antibiotikum verabreicht. Häufig wird zur Reduktion der Eosinophilen Cortison eingesetzt.
Die Behandlung des idiopathischen Hypereosinophilie-Syndroms erfolgt mit Medikamenten wie Cortison, Hydroxyurea oder Chemotherapeutika.
Eine Eosinopenie wird meist nur zufällig im Blutbild entdeckt und verläuft in der Regel problemlos. Andere Zellen des Immunsystems können den Mangel ausgleichen. Sobald die Ursache beseitigt ist normalisiert sich der Blutwert wieder.
aktualisiert am 02.03.2022